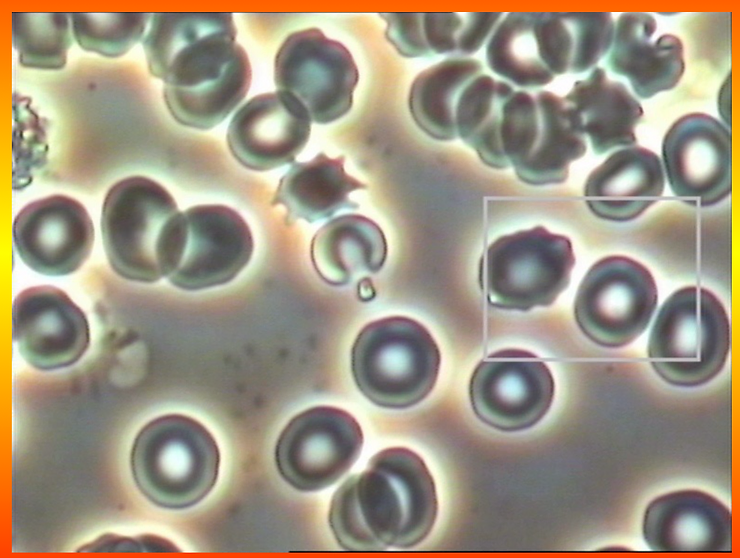

Are Corona Cells Caused from a Viral Infection or from a Toxic Acidic Internal Environment?
Updated: Mar 17, 2020

Corona cells are the result of cellular biological transmutation due to an acidic lifestyle and diet.
I have seen Corona type cells primarily in those who are in decompensated acidosis of the colloidal connective tissues of the schade or what today scientists call the interstitial fluids of the Interstitium.

After 40 years of viewing body cells under a compound microscope using dark field, phase contrast, bright field and electron microscope, I have watched body cells go through biological transmutations/genetic mutations, evolve and breakdown in a declining pH environment (from 7.365 to 7.3 to 7.2 to 7.1 and then the death of the cell) without any outside influence from a so-called viral infection, with the so-called presumptive Coronaviurs.

In fact, Corona type cells are the result of an internal acidic environment due to an inverted way of living, eating, breathing, thinking, feeling and believing.
In addition, Corona type cells are found more predominately in those individuals who ingest the blood and flesh of animals, including beef, chicken, turkey, duck, pork and fish.
Finally, those persons who are exposed to excessive electromagnetic frequencies (EMF) that exceed 100 mG or 60 GHz are also at risk for cellular and genetic mutations. All the symptoms of EMF poisoning are the same as the symptoms for the presumptive Coronavirus.

Toxic EMF frequencies are emitted from cell towers, cell phones, WiFi, airplane engines, electric cars, hair dryers, computers, microwaves, especially 5G pulsating V or Virus frequencies starting at 60 GHz up to 100 GHz.

EMF is one of the main causes for cellular and genetic mutations leading to sickness, disease and death.
There are many other acidic poisons that are causing corona cells, such as the chemical pesticide glyphosate or the many chemical poisons in vaccines.


To learn more about my 40 years of work, research, findings and peer-reviewed publications on viruses, vaccines and the viral theory go to: https://staging.drrobertyoung.com/post/dismantling-the-viral-theory
The micrographs below are pictures of red and white blood cells biologically transforming and giving birth to cell membrane appendages (called baterio pHages or vesicles), appearing like a crown. This is the corona stage within the life cycle of a red blood cell or any body cell that is breaking down due to an environmental compromise in the biochemistry within (interstitial fluids) and without the cell (intracellular fluids). This is not the work of a non-living so-called presumptive Coronavirus but a change in the delicate pH balance of the internal fluid environment – especially the Interstitium organ that cntain the interstitial fluids that surround every cell in the human body and pass through every organ and organ system. In other words, the germ is nothing and the terrain is everything.

The genesis for health, energy and vitality and ALL sickness and disease begins in the sea of L.I.F.E. – the living interstitial fluid environment

To determine the health of the body it is important to understand that you need to test the interstitial fluids that make up 80 percent of the extracellular fluids. The blood only makes up only 20 percent of the extracellular fluids and will only give you 20 percent of your health picture.

Appointments can be made for testing by emailing: universalmedicalimaging@gmail.com or calling: 818-987-6886. The Life Test or Living Interstitial Fluid Environment Test is the only non-invasive and non-radioactive test and is the missing link to understanding your complete health condition.

To learn more about the genesis of YOUR health and vitality and how to prevent or reverse ALL sickness and disease go to: www.drrobertyoung.com
Read the truth about viruses, vaccines and the viral theory:
-
https://staging.drrobertyoung.com/post/dismantling-the-viral-theory
-
https://staging.drrobertyoung.com/post/fear-mongering-or-facts
-
https://staging.drrobertyoung.com/post/18-different-ways-to-reverse-the-symptoms-of-so-called-coronavirus-with-the-phour-salts
-
https://staging.drrobertyoung.com/post/purified-alkaline-water-with-puriphy-for-ultimate-environmental-protection
-
https://staging.drrobertyoung.com/post/reduced-hydrogen-or-molecular-hydrogen
-
https://staging.drrobertyoung.com/post/are-you-prepared-for-the-bio-hazardous-effects-from-5g-emf-radiation
-
https://staging.drrobertyoung.com/post/the-truth-about-viruses-including-the-coronavirus
-
https://staging.drrobertyoung.com/post/protect-yourself-from-environmental-acids-viruses-like-corona-flu-for-true-immunity
-
https://staging.drrobertyoung.com/post/do-germs-like-the-coronavirus-cause-disease

PS Always remember disease and sickness is born in us and from us. There are no infectious diseases just outfectious symptomologies caused by what we eat, what we drink, what we breathe, what we think, what we feel and what we believe.
